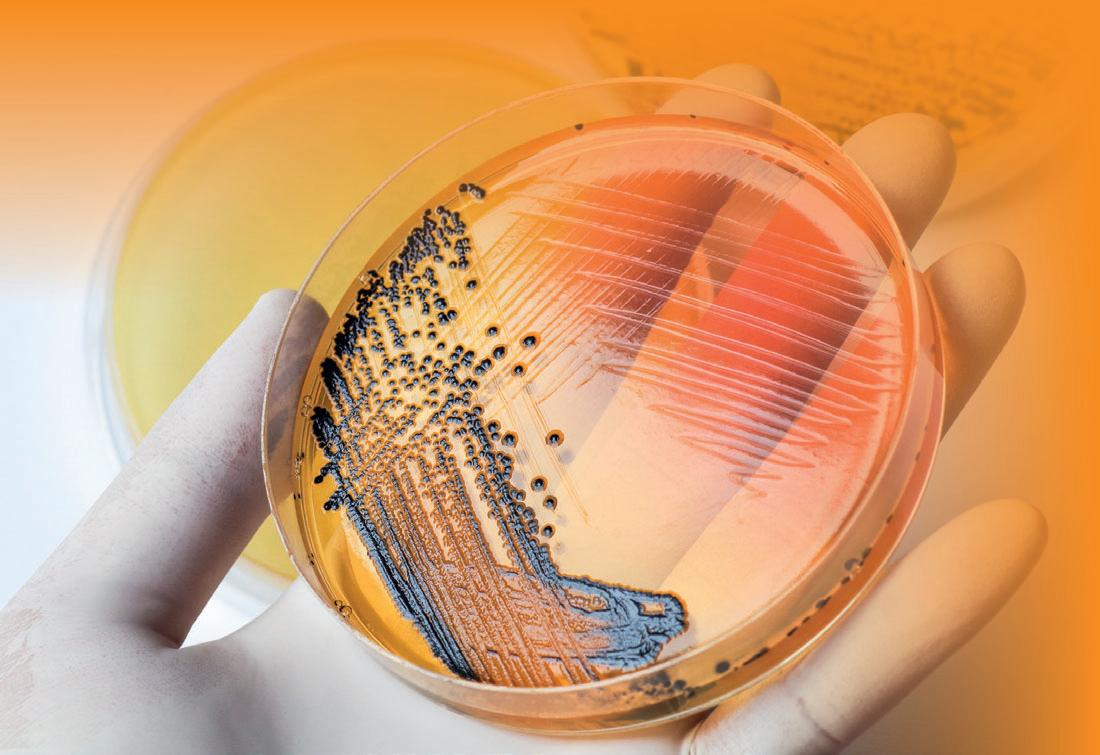

Because good breeders... also listen

40-70%
















































































































































































GRUPO DE COMUNICACIÓN AGRINEWS LLC
Luis Carrasco
+34 605 09 05 13
Diego Carrasco
+34 635 45 82 93
Dr. Magida Corby
+1 334 524 9996
Mercé Soler
Dr. Magida Corby
aviNews Legal Deposit B11597-2013
Noun Project/Freepik/Dreamstime:




We connect you with your client in every language, we connect you anywhere in the world

























































































































































